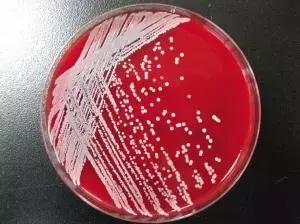
我这手怎么就这么贱呢表情包,手好贱

图片来源:网络
作者 | loop
你是痘肌吗?
你平时长痘痘吗?
如果长了痘痘你会挤吗?
你也是“不挤痘会死”星人吗?
从现在开始
求求各位别再手贱了!
挤痘痘这种事情
真的会闹出人命!

前几天
江苏一位小姐姐的嘴唇上方长了个痘痘
作为年轻爱美的姑娘
怎么能允许痘痘的存在?
于是她当即露出双手
想要把痘痘挤掉

挤痘痘是一件再平常不过的事情
可这次却不大一样
挤完没多长时间
她突然发现自己的嘴唇越来越厚
左脸也开始严重肿胀
连左眼皮都抬不起来
后面渐渐发展成高烧不退
最后竟被送入了icu病房

据医生描述
小姑娘进医院的时候
体温已经达到了惊人的40度
处于叫不醒的昏睡状态
呼吸和心率都很快
并伴有大小便*禁失**
情况非常危急

医生一看这状况
立马给她做了磁共振、胸部CT等
结果出乎意料
小姑娘不光脑部信号异常
还有双侧肺炎
胸腔有少量积液

医生也感到很奇怪
原本健健康康的小姑娘咋突然变成这样了
后来经机智的医生研究发现
问题就出现在那颗被挤掉的痘痘上
因为那颗痘痘
偏偏就长在最最最危险的三角区……
三角区这个词
很多人都听说过
但大多数人根本就不知道它的危险
有不少人像这个江苏姑娘一样
因为忽视它
差点把小命玩完…

29岁的小喻的嘴边也长过一颗痘痘
结果嘴唇越来越红肿
右眼也肿了起来
送到医院的时候
状况已经很危险了

炎症开始在他的体内扩散
眼睛和肺部都开始出现严重感染
后来经医生诊断
小喻正是因为抠了三角区的痘痘
从而引发败血症
如果更严重的话
会导致海绵状筋膜炎
导致颅内感染
死亡率非常高…

钱江一位50岁的大叔
也曾因为挤痘痘住进了ICU
他不光有口腔感染和败血症
更出现了器官衰竭的迹象
医生曾两次下达病危通知书
抢救了整整五天才让他脱离危险…

痘痘看上去小小的
感觉很无害
但真的不能随便挤
尤其是三角区
因为面部三角区的血管非常丰富
这个区域的痘痘最好不要挤
也不要用粉刺针去挑
特别是当双手未洗净
或者指甲太长,手部没有消毒的时候
细菌一旦进入血液
就会引起面部感染
产生严重的并发症

医生建议
可以涂一些碘伏
或者用一些抗生素软膏
有条件的话尽可能去正规医院就诊
不要自己在家里瞎折腾

而不光是三角区
痘痘这种东西
还有可能是疾病的预兆
加拿大小哥沃德今年23岁
他已经连续好多年不长痘痘了
结果有一天早上起床
他到卫生间洗漱的时候
突然发现自己长了一颗又红又肿的痘痘
上面还有白色的小脓包

沃德一摸
谁知道这痘还有点疼
但他也没多想
随便涂了点药就去上班了
下班回家后
小哥第一件事就是照镜子
结果却发现脓包竟然长大了!
腮帮子又疼又肿
用冰袋冷敷也不好使!

沃德一看情况不对
当即做了一件事
没错
他挤了

不挤不知道
一挤吓一跳
这脓包的数量之多
根本挤不干净!
又长又粗就像蛆虫
沃德一边忍着恶心一边挤…
“我滴妈呀!
天知道我当时有多想吐!”

不过俗话说得好
男人的嘴,骗人的鬼
就算他嘴上说恶心
但还是把脓包挤干净了
挤完后
他把这一坨带到医院
让医生拿去化验
你猜怎么着?
原来沃德被葡萄球菌感染了!

你别看葡萄球菌这个名字萌萌哒
严重的话可能会危及生命
沃德算是比较幸运的一个
因为他通过痘痘及时发现了身体的异样
而有些不幸的人
他们的器官或血液受到了这种病菌的感染…
这种病菌听上去虽然有点可怕
但其实可以在人的皮肤上被发现
如果你在皮肤上发现了以下症状
可以考虑去医院检查一下~
如果你的皮肤上有红色的肿块
脸部、腿部、脖子或者脚上等部位
这种情况就有可能是被感染了

还有一种感染情况是出现发烧
或者身上出现水泡皮疹
有时水泡发生破裂
看起来就像烧伤一样
这种情况多见于脆弱的婴儿或儿童

还有就是像加拿大的沃德小哥一样
身上某一部分有化脓性肿胀
也可以考虑去医院检查一下
而在血液中发生的葡萄球菌感染
则可能会影响心肺等器官
甚至是脑部

另外
脸上不同位置长痘
也对应着不同的器官
鼻子长痘的话
建议少吃辛辣刺激性食物
保护好自己的肠胃
额头长痘可能是心火过旺
要调整自己的心情和脾气
保证足够的睡眠
让身体放松

太阳穴长痘可能是胆囊堵塞
可以多吃些黄瓜、苦瓜、冬瓜这样的食物
来帮助你更好地吸收油脂
不过呢
脸上长痘痘也不用太紧张
说不定你的身体没什么问题
只是青春期还没过而已

不过话说回来
关于痘痘这种问题
最重要的还是在于能不能挤
痘痘不是不能挤
但是要有策略性地挤
三角区不要挤!
三角区不要挤!
三角区不要挤!
三角区,
真的不要挤!
记住了吗?


爱长痘的人
一定要好好看看这篇推送
保命!